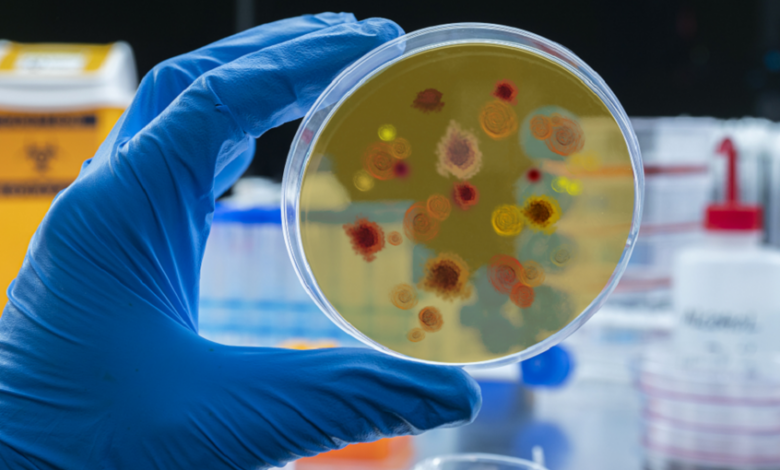

لقاح مبتكر ضد الملاريا يحقق نجاحا أوليا مذهلا
روافدنيوز/متابعة
كشف فريق دولي من الباحثين عن لقاح جديد ضد الملاريا، المرض الذي يسببه طفيلي ينتقل إلى الإنسان عن طريق البعوض المصاب.
وفي عام 2024، أصيب نحو 282 مليون شخص بالملاريا، وتوفي 610 آلاف منهم، وفقا لمنظمة الصحة العالمية، ويعدّ المرض سببا رئيسيا لوفيات الأطفال دون سن الخامسة.
وباستخدام تقنية مصدر الضوء الكندي (CLS) في جامعة ساسكاتشوان، طوّر الباحثون من كندا والولايات المتحدة وهولندا لقاحا جديدا أظهر نتائج واعدة في التجارب ما قبل السريرية.
وأوضح دانتون إيفانوشكو، الباحث في مستشفى الأطفال المرضى (SickKids) في تورنتو والمعد الرئيسي للدراسة، قائلا: “هدفنا هو القضاء على الملاريا من خلال تصميم لقاح أكثر فعالية من اللقاحات المتوفرة حاليا”.
وخلال الدراسة، فحص الفريق عينات دم من أشخاص اكتسبوا مناعة طبيعية ضد الملاريا، وتمكنوا من تحديد البروتينات في الطفيلي التي تلعب الدور الأكبر في انتقال العدوى. ومن خلال دمج أقوى جزأين من الطفيلي في اللقاح الجديد، لاحظ الباحثون تحفيز استجابات مناعية أقوى بكثير مقارنة باستخدام كل بروتين على حدة.
واستخدم الباحثون تقنية CLS لرسم خريطة بنية الأجسام المضادة البشرية المرتبطة باللقاح، ما أكّد فعالية تصميمه على المستوى الجزيئي، وساعد في تقليل الشكوك قبل الانتقال إلى التجارب السريرية المكلفة.
وسيخضع اللقاح لمزيد من الاختبارات، وإذا استمر في الأداء القوي، فقد ينتقل إلى التجارب السريرية خلال بضع سنوات.
وقال إيفانوشكو: “نتطلع لمعرفة أداء اللقاح في المرحلة التالية، ونأمل أن نساعد ملايين الناس الذين يعانون من نقص الخدمات الصحية، وأن نساهم في القضاء على الملاريا عالميا”.
نشرت نتائج الدراسة في مجلة Nature Communications./انتهى



